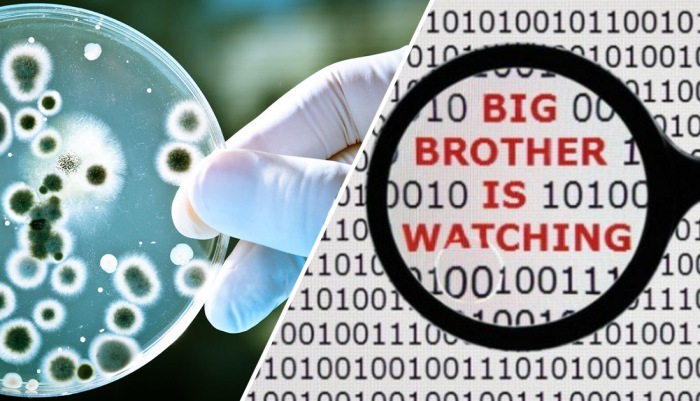

Глобальные катастрофы, которые могут произойти на Земле в любой момент.
Наш мир хрупок, как стекло. На самом деле практически в любой момент, может произойти нечто, что станет для человечества настоящей глобальной катастрофой. Кометы, техногенные катастрофы, войны и даже бактерии могут поставить существование жизни на Земле под угрозу.
1. Устойчивые к антибиотикам бактерии

Бактерии против антибиотиков.
Поскольку люди постоянно принимают разнообразные антибиотики, бактерии также постоянно мутируют и у них развивается иммунитет. Это всего лишь вопрос времени, когда закончатся все прежде средства лечения заболеваний, которые раньше было очень просто излечить.
2. Мега-засуха

Глобальная засуха — угроза для человечества.
Сегодня невозможно предсказать, что случится с планетой, ясно только одно — климат станет намного более сухим. Наихудший вариант развития событий, однако, может привести к мега-засухе во многих странах в ближайшие 100 лет.
3. Йеллоустоун
Йеллоустонский национальный парк
Если кто не знает, то Йеллоустонский национальный парк в США на самом деле является огромным супер-вулканом, который в любой момент может «расплавить» всю Северную Америку.
4. Западно-антарктический ледяной покров

Таяние льдов.
Ученые считают, что западно-антарктический ледяной покров достиг точки «неизбежного разрушения». Если он растает, то уровень моря поднимется на 1,2 метра. Единственное, что ученые не знают, это насколько быстро будет таять лед.
5. Саудовская Аравия

Саудовская Аравия: грядёт ли экономический коллапс?
Если спросить у любого жителя Саудовской Аравии, то он скажет что-то вроде «мы когда-то были пастухами, и мы снова будем пастухами». Экономика страны почти полностью зависит от нефти и иностранной рабочей силы. А если объединить это с ожиданием экономического коллапса и растущей жесткостью радикального ислама, то получится настоящий рецепт катастрофы, похлеще Сирии.
6. Озеро Таупо

Озеро Таупо.
Это самое большое озеро в Новой Зеландии, которое расположено в кратере вулкана, «подарившего» Земле самое крупное извержение в ее истории (Извержение Оруануи 26000 лет назад). Это лишь вопрос времени, когда вулкан снова проснется.
7. Сейсмические зоны

Сейсмические зоны.
Это сейсмическая зона на юго-востоке Соединенных Штатов, которая вызвала Нью-Мадридское землетрясение 1812 года и кучу мелких землетрясений с тех пор. По данным американского Федерального агентства по чрезвычайным ситуациям, серьезное землетрясение в Нью-Мадридской сейсмической зоне может привести к «ужасным экономическим потерям в Соединенных Штатах» и нанести «катастрофический ущерб» всей Алабаме, Арканзасу, Иллинойсу, Индиане, Канзасу, Кентукки, Миссисипи, Миссури, Оклахому, Техасу и Теннесси.
8. Стамбул

И даже в Стамбуле могут быть землетрясения.
Оказывается, зона Стамбула также небезопасна с точки зрения землетрясений и извержений вулканов. Что гораздо печальнее, этот район является чрезвычайно населенной областью с очень плохой инфраструктурой.
9. Мосульская плотина

Мосульская плотина.
Эта плотина в Ираке страдает проблемами с самого времени его создания. Теперь же, что еще хуже, она находится под контролем ИГИЛ. Если потрескавшаяся плотина рухнет, погибнет минимум полмиллиона человек.
10. Кислотные океаны

Кислотные океаны
Мало того, что углекислый газ приводит к глобальному потеплению, так он еще и вступает в реакцию с водой с образованием угольной кислоты. Если в двух словах — все живое в океанах может погибнуть.
11. Вмешательство в частную жизнь

Расслабьтесь, за вами следят!
Это уже происходит. Медленно, но очень уверенно. Чтобы понять, чем это закончится, стоить просто прочесть роман «1984».
12. Канарские острова

Канарские острова.
Ученые предупреждают, что извержение вулкана на Канарских островах может создать мега-цунами, которое будет обладать достаточной силой, чтобы уничтожить целые города на побережье Атлантического океана.
13. Сычуань

Сычуань, который может исчезнуть.
В пойме реки здесь живут почти 80 миллионов человек. Здесь, как и в Мосуле, есть плотина, которая сдерживает более 1 млрд кубических метров воды. И, как несложно догадаться, в ней есть трещины.
14. Ядерная война

Ядерная война.
Рядом с современным ядерным оружием Хиросима и Нагасаки покажутся детскими игрушкам. Если развязать ядерную войну, с человечеством будет гарантированно покончено.
15. Истощение нефти

Истощение нефти
Это правда. Благодаря новым методам добычи, в мире сегодня есть гораздо больше нефти, чем все думали раньше. Проблема заключается в том, что нефть все же не вечна. И рано или поздно она закончится.
В продолжение темы мы расскажем про 7 самых масштабных природных катастроф последнего десятилетия.
Источник: